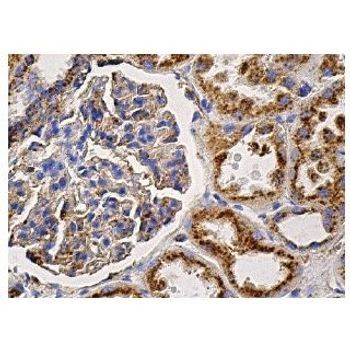

Santa Cruz Biotechnology is a world leader in the development of products for the biomedical research market. Over the past 30+ years, the Company has focused on the ongoing development of research antibodies, siRNA and CRISPR Gene editing tools, biochemicals, labware and more recently has expanded into animal health care products. Santa Cruz Biotechnology has the highest commitment to quality and customer service.
LAMP-2 (H4B4) | Santa Cruz Biotechnology
mouse monoclonal IgG1; LAMP-2 Antibody (H4B4) is an IgG1 κ mouse monoclonal LAMP-2 antibody (also designated LAMP2 antibody, LAMPB antibody or lysosomal associated membrane protein 2 antibody) that detects the LAMP-2 protein of human origin by WB, IP, IF, IHC(P) and FCM. LAMP-2 Antibody (H4B4) is available as both the non-conjugated anti-LAMP-2 antibody form, as well as multiple conjugated forms of anti-LAMP-2 antibody, including agarose, HRP, PE, FITC and multiple Alexa Fluor® conjugates. Lysosome-associated membrane proteins (LAMP) are glycosylated type I membrane proteins that play a role in the biogenesis of the pigment melanin. LAMP-1 (also designated CD107A) and LAMP-2 (also designated CD107B) are involved in a variety of functions, including cellular adhesion, and are thought to participate in the process of tumor invasion and metastasis. Newly synthesized LAMP-1 and LAMP-2 proteins are sorted at the trans Golgi network and are transported intracellularly via a pathway that is distinct from the clathrin-coated vesicles used for the mannose-6 phosphate receptor. LAMP-1 is expressed on the surface of thrombin-activated but not resting platelets, and it is thought to be involved in the adhesive, prothrombic properties of these cells. Both LAMP-1 and LAMP-2 are involved in maintaining lysosome acidity and protecting the lysosomal membranes from autodigestion, and their expression is increased in patients with lysosomal storage disorders.





























































